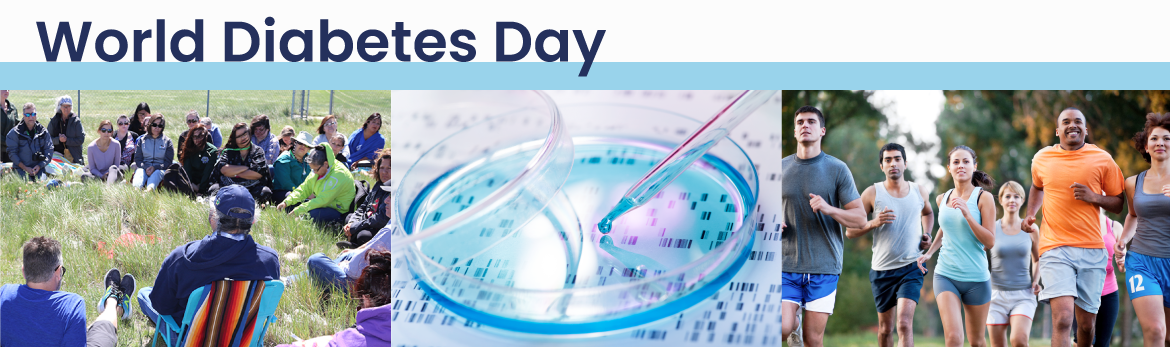
World Diabetes Day

Message from Dr. Norman Rosenblum on World Diabetes Day
On November 14, World Diabetes Day was marked to raise awareness about diabetes and the complications caused by the disease—a chronic condition that occurs when the body is either unable to produce or properly use insulin. The prevalence of diabetes in Canada is increasing, and with more than three million Canadians living with diabetes, there is an urgent need to decrease the burden of diabetes on individuals, families, and health care systems.
As the 100th anniversary of the discovery of insulin approaches, we recognize Canada’s international leadership in diabetes research, and we reflect on the impact of scientific discoveries on the lives of Canadians living with diabetes. The Canadian Institutes of Health Research (CIHR) is the largest funder of diabetes research in Canada, and the CIHR Institute of Nutrition, Metabolism and Diabetes (INMD), which I serve as Scientific Director, continues to champion diabetes research.
Most recently a new research initiative was launched under the leadership of CIHR-INMD, as well as the Institutes of Genetics (IG), Indigenous Peoples’ Health (IIPH), and Infection and Immunity (III), in collaboration with many other CIHR institutes and with national and international partners, to celebrate the 100th anniversary of the discovery of insulin to be marked in 2021—100 Years of Insulin: Accelerating Canadian Discoveries to Defeat Diabetes. Through this initiative, new Canadian research teams will be funded to improve our understanding of the mechanisms that control the onset and progression of all types of diabetes mellitus and related complications, and to develop new and more effective strategies aimed at prevention, treatment, and delivery of care for people living with diabetes in order to reverse the upward trend in diabetes prevalence and associated complications, and reduce the impact of diabetes on individuals, families and communities.
As part of this initiative, a new partnership between CIHR and UK research funders was developed to fund six world-leading collaborative UK-Canada Diabetes Research Teams . We will also soon announce the results of two other competitions: a new research consortium that will enable leading researchers in Canada and the Netherlands to tackle type 2 diabetes, and new funding for research teams to accelerate stem cell-based therapies for the treatment of type 1 diabetes in collaboration with JDRF Canada. We are excited that CIHR has recently re-launched, Team Grants: Diabetes Mechanisms and Translational Solutions. CIHR will also support Indigenous-led and community-driven research that aims to reverse the increase in diabetes and associated complications among First Nations, Inuit and Métis Peoples and their communities through the recently launched Team Grants in Diabetes Prevention and Treatment in Indigenous Communities: Resilience and Wellness.
I am extremely grateful for the support of colleagues at CIHR who have contributed to the development and implementation of this exciting new initiative, and to our partner organizations, such as Diabetes Canada, Fonds de recherche du Québec–Santé (FRQS), Génome Québec JDRF Canada, Kidney Foundation of Canada (KFOC) and Mitacs, and our international partners, who have also contributed to this new initiative.
The COVID-19 pandemic has created an additional challenge for individuals with pre-existing conditions such as diabetes who are more severely affected and has served to highlight the critical importance of science and the health research enterprise in Canada and globally. We must redouble our efforts through research to find more effective diabetes prevention and treatment strategies, and ultimately, a cure for diabetes.
Dr. Norman Rosenblum, MD, FRCPC
Scientific Director
CIHR Institute of Nutrition, Metabolism and Diabetes
Associated Links
- 100 Years of Insulin: Accelerating Canadian Discoveries to Defeat Diabetes
- Team Grant: UK-Canada Diabetes Research Team Grants
- Team Grant: Netherlands-Canada Type 2 Diabetes Research Consortium
- Team Grant: CIHR-JDRF - Accelerating Stem Cell-Based Therapies for Type 1 Diabetes
- Team Grant Diabetes Mechanisms and Translational Solutions
- Team Grants in Diabetes Prevention and Treatment in Indigenous Communities: Resilience and Wellness
- 100 Years of Insulin: Featured Research
- Pathways to Health Equity for Aboriginal Peoples
- Strategy for Patient-Oriented Research
- Government of Canada and JDRF join forces to defeat diabetes
- World Health Organization: Diabetes
- Date modified: